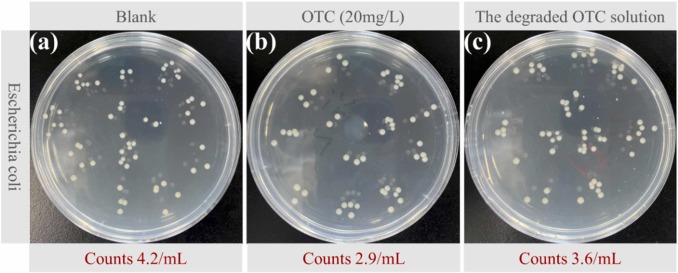
4.jpg 4.jpg

新型无机纳米材料的绿色可控合成
设计合成新型高效电催化剂用于能量转化与存储
生物医用功能为导向的纳米材料的设计合成与性能研究
近期研究成果:
1. Entropy-guided discovery of denary trirutile antimonates for electrocatalytic chlorine evolution.
Tian (Leo) Jin, Pin Chen, Jingtao Wang, Yuan Yu, Yue Gong, Qiang Zheng, Tianxing Wang, Yutong Lu, Rongqian Wu, Jie Chen, Yi Lyu*, Shaohua Shen*, Xiaofei Liu*.

Joule, 2025, 2542-4351. LINK
该工作被西安交通大学新闻网 LINK、西安交通大学医学部 LINK、西安交大一附院 LINK、国家超级计算广州中心 LINK、外科梦工场 LINK 报道。
2. Electronic Microenvironment Regulation of Bismuth-salophen Single-site Catalysts for Enhanced Selectivity in CO2 Electrolysis to Formic Acid.
Tianxing Wang, Tian(Leo) Jin*, Zhiping Liu, Jingtao Wang, Yue Gong, Ming Ma, Jie Chen*, Shaohua Shen, Rongqian Wu, Yu-Cheng Huang, Ying Rui Lu, Yi Lyu*, Xiaofei Liu*.

Advanced Science, 2025, e02061.LINK
3. Copper-Based Nanotubes That Enhance Starvation Therapy Through Cuproptosis for Synergistic Cancer Treatment.
Xuan Han, Xin Zhang, Zhiping Liu, Hang Liu, Derek Wu, Yinli He, Kexin Yuan, Yi Lyu*, Xiaofei Liu*.

Advanced Science, 2025, e04121. LINK
4. Oxygen-enriched vacancy spinel Mn-Co oxides by deep thermal reduction for enhanced antibiotics degradation efficiency.
Xiai Zhang, Rui Zhou, Ruohong Bi, Tong Wang, Qikui Fan, Hao Zhu, Zhimao Yang, Xiaofei Liu*, Chuncai Kong*.
Journal of Environmental Chemical Engineering, 2024, 111988. LINK
5. Distinctive p-d orbital hybridization in RuSb nanobranches for simultaneously enhanced hydrogen evolution and hydrazine oxidation in alkaline seawater.
Liu, X., Wang, T., Chen, Y., Wang, J., Xie, W., Wu, R., Xu, X., Pang, L., Zhang, X., Lv, Y., Wang G., Yamauchi, Y.*, Jin, T.*

Applied Catalysis B: Environmental, 2023, 333, 122771. LINK
6. Mechanochemical-tuning size dependence of iridium single atom and nanocluster towards highly selective ammonium production.
Jin, T., Wang, J., Gong, Y., Zheng, Q., Wang, T., Wu, R., Lyu, Y.*, Liu, X.*

该工作被 CellPress(LINK)报道。
Chem Catalysis, 2023, 3(1), 100477. LINK
7. Pyrolysis-free, facile mechanochemical strategy toward cobalt single-atom/nitrogen-doped carbon for highly efficient water splitting.
Jin, T., Liu, X. (co-first author)*, Gao, Q., Zhu, H., Lian, C., Wang, J ., Wu, R., Lyu, Y.

该工作被西安交通大学新闻网(LINK)、西安交通大学医学部(LINK)、精准外科与再生医学国家地方联合工程研究中心(LINK)报道。
Chemical Engineering Journal, 2022, 433, 134089. LINK
8. Mesoporous carbon-supported ultrasmall metal nanoparticles via a mechanochemical-driven redox reaction: A “Two-in-One” strategy.
Jin, T., Liu, X. (co-first author)*, Su, Y., Pan, F., Han, X., Zhu, H., Wu, R., Lyu, Y.

该工作被西安交通大学医学部(LINK)、搜狐网(LINK)、丁香园(LINK)、精准外科与再生医学国家地方联合工程研究中心(LINK)报道。
Applied Catalysis B: Environmental, 2021, 294, 120232. LINK




